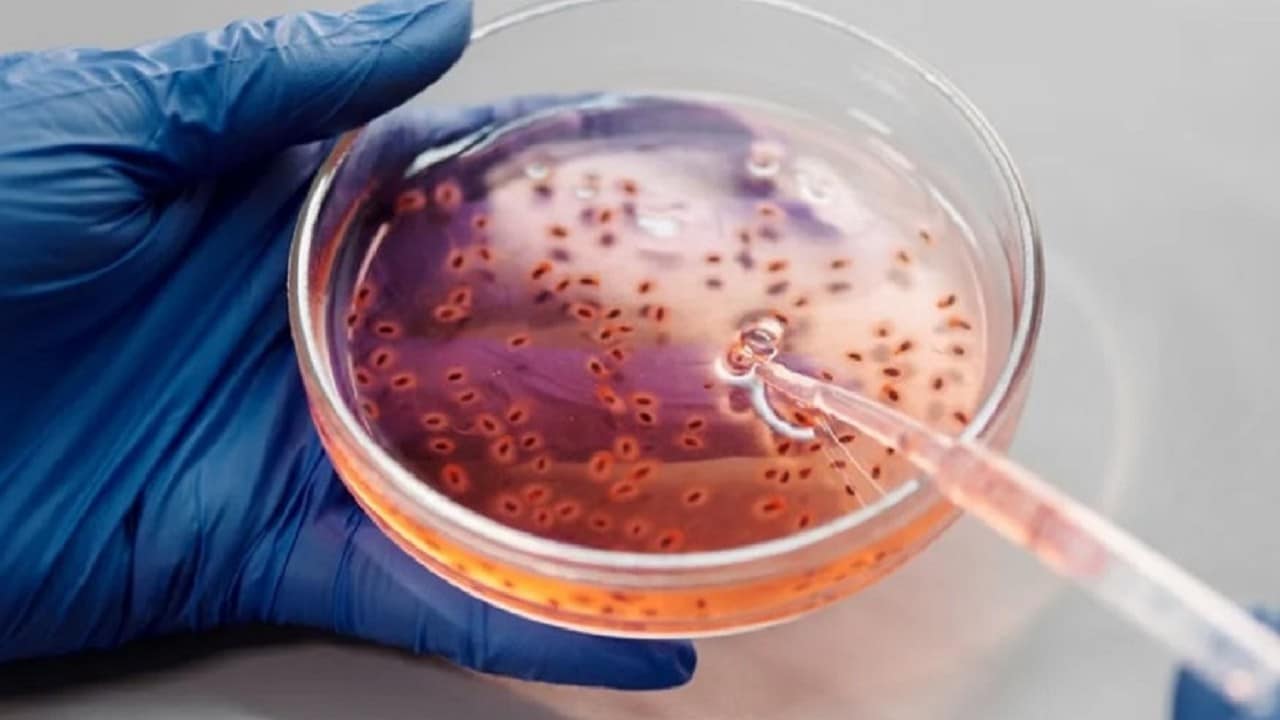

México reporta 118 nuevos casos de viruela del mono para un total de 504
Ciudad de México (Marcrix Noticias).- El Gobierno mexicano reportó este martes 118 nuevos casos de viruela del mono detectados en la última semana, con lo que el país totaliza 504, aunque aún no confirma ninguna muerte relacionada.
En su informe técnico semanal, la Secretaría de Salud apuntó que hasta el 29 de agosto se notificaron 1,146 casos sospechosos de viruela símica, de los que 504 están confirmados, 252 bajo estudio y 390 se descartaron.
Los contagios en la última semana son menores a los 134 documentados una semana anterior.
En total, los casos se han detectado en 25 de los 32 estados mexicanos, el 97% de ellos fueron hombres y el 47% de contagios corresponden a personas entre los 30 años y los 39 años.
Además, Ciudad de México es la de mayor afectación, con 279 casos positivos confirmados.
Le siguen Jalisco, con 84; Estado de México, con 31; Yucatán, con 29; Quintana Roo con 14; Baja California, Chiapas y Nuevo León con 9.
Entretanto, se registraron 5 en Veracruz; 4 en Guanajuato, Puebla y Tabasco; 3 en Chihuahua, Morelos, Querétaro; 2 en Colima Oaxaca, Sinaloa, Sonora, y 1 en Baja California Sur, Coahuila, Michoacán, Zacatecas, San Luis Potosí y Aguascalientes.
Asimismo, el Informe Técnico Semanal de la Vigilancia Epidemiológica de Viruela Símica en México reportó una defunción de una persona con choque séptico, neumonía adquirida e infección por VIH, “quien durante su atención médica se identificó con lesiones compatibles con viruela símica”.
“Al practicarle la prueba resultó positiva. La defunción se analiza con detenimiento por parte un grupo de personas expertas en infectología para dictaminar si existe causa atribuible a la infección por virus de la viruela símica”, acotó la Secretaría de Salud.
A finales de julio, el subsecretario de Prevención y Promoción de la Salud, Hugo Lopez-Gatell, negó que esta enfermedad vaya a propagarse “extensamente en el país”, pese a que la Organización Mundial de la Salud (OMS) declaró alerta máxima por el aumento de casos de viruela símica en el mundo.
De acuerdo con la OMS, hasta la fecha se han registrado más de 35,000 casos de esta enfermedad en 92 países, así como 12 defunciones.
Activistas han denunciado que el Gobierno mexicano minimiza el brote, omite comprar vacunas e ignora el peligro que representa para poblaciones vulnerables.
Sin embargo, López-Gatell aseguró que México ya sigue las medidas recomendadas por la OMS.
Con información de Forbes
👉Síguenos en Facebook
MarcrixNoticias👇
https://www.facebook.com/MarcrixNoticias1/